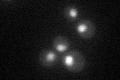
YML113W
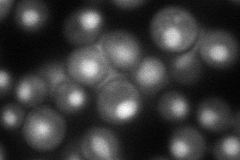
YML113W
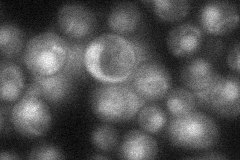
YML113W
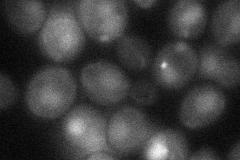
YML113W

View description
DNA binding protein that recognizes oligo(dA).oligo(dT) tracts; Arg side chain in its N-terminal pentad Gly-Arg-Lys-Pro-Gly repeat is required for DNA-binding; not essential for viability
Localization:
Intensity:
Fold change:
Significance:
-
C’ GFP library in SD
nucleus37.85 -
N' NOP1pr-GFP in SD

nucleus66.9302 -
N' TEF2pr-mCherry in SD
nucleus65.4116 -
N' NATIVEpr-GFP in SD
nucleus34.1173 -
N' TEF2pr-VC and Cyto-VN in SD
nucleus35.6693 -
C’ GFP library in SD+DTT

nucleus32.970.87No -
C’ GFP library in SD+H2O2

nucleus30.350.8No -
C’ GFP library in Starvation Media

nucleus25.570.67Yes -
C’ GFP library on the background of Pup2-DaMP

nucleus -
C’ GFP library on the background of CCT mutant

nucleus36.48870.963935No
